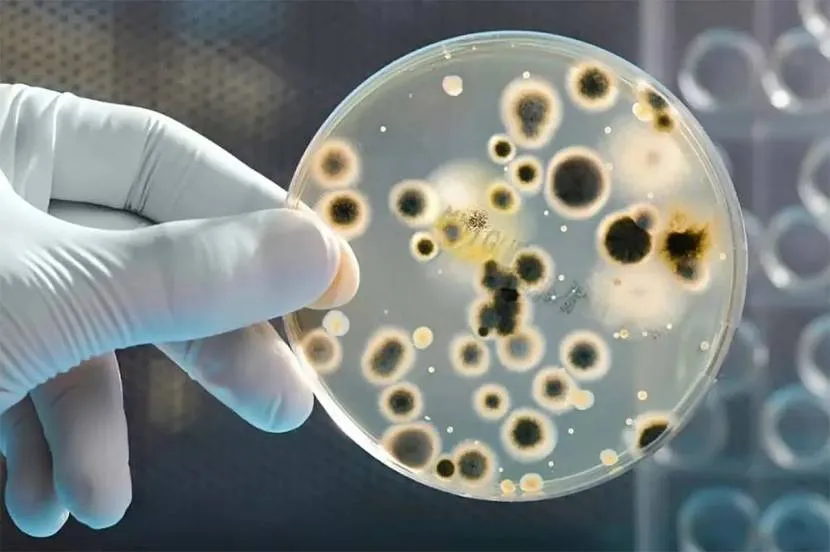

Что собой представляет очистка
Этот процесс осуществляется при помощи специальных реагентов, которые устраняют все отложения, в том числе и мочекаменные. Далее проводится новая заправка емкости специальной дезинфицирующей жидкостью. После чего поверхность кабины обрабатывается антисептиком, а внутри нее делается химическая обработка.

работы по очистке МТК
Обслуживание МТК следует осуществлять регулярно. Как часто это будет делаться, зависит от количества пользователей. Обычно очистка туалетных кабин проводится один или два раза в месяц. Дезинфицирующая жидкость свои качества сохраняет на протяжении 3-4 месяцев. Поэтому, даже если кабина бездействовала какое-то время, ее все равно следует очищать, чтобы она могла исправно функционировать дальше.
Обслуживание МТК – это весь комплекс работ, направленный на поддержку их работоспособности. В эти работы входит и откачка, тогда как очистка является дополнительным действием, проводимым для устранения мочекаменного налета на стенках и дне накопительного бака.
Жидкость для мобильных кабин

Использование специальной жидкости
В современных устройствах применяются специальные химические санитарные вещества, нейтрализующие все неприятные запахи и замедляющие процессы разложения. Туалетная жидкость не только борется с нехорошими ароматами, но и дезинфицирует емкость. Также она используется для дезодорации выгребных ям и обычных дачных клозетов.
Жидкость, применяемая для туалетных кабинок, может иметь синий или зеленый цвет, но это на ее свойства, как антисептика, никак не влияет.
Также на выбор предлагается несколько вариантов запаха, это может быть аромат ванили, хвои, дюшеса, эвкалипта и т.д.Заливаемая в бак жидкость, сначала разбавляется в пропорции: 200 мл химического реагента на 10 л воды. Одного литра раствора достаточно для переработки 15 л нечистот.
Следует иметь в виду, что в состав санитарных препаратов входят некоторые вещества, представляющие опасность для здоровья человека. Поэтому работать с ними следует в резиновых перчатках и не допускать попадания капель в глаза или на кожу. Если это все-таки произошло, то жидкость с тела смывается холодной чистой водой.
Зимой очистка мобильных туалетных кабин осуществляется с применением специальных препаратов, препятствующих замерзанию отходов в накопительном баке. При сильных морозах дезодорирующая жидкость полностью сохраняет свои ценные качества.
Основные производители жидкостей для МТК
Концентрированная жидкость Turbo Tubes
На сегодняшний день на отечественном рынке представлены в большом количестве средства как зарубежных, так и российских производителей. Они отличаются не только стоимостью, но и составом, что необходимо учитывать при выборе.
Самыми эффективными считаются препараты, производимые канадской компанией Septicsol и голландской фирмой Aqua Rinse.
Они отличаются высоким уровнем переработки отходов жизнедеятельности.Популярность приобрела и жидкость для туалетных кабинок Turbo Tubes, производимая в США.
Препарат Биола
Но чаще всего бак для туалетной кабины купить заливают отечественным препаратом Биола, купить который можно намного дешевле, чем импортный аналог, так как 1л его обходится всего в 230 рублей.
Не уступает ему по стоимости и свойствам дезодорирующее средство МультиСан, цена за 1 л которого также находится в пределах 300 рублей. Хорошо себя зарекомендовала компания «Хемилайн», которая выпускает линию средств для биотуалетов ЛАЙНА.
Выводы
Следует отметить, что не всякое химическое средство пригодно для очистки биотуалета. Простая бытовая химия с этой задачей не справится. Более того, ее использование может привести к нежелательным последствиям. Чистка мобильных туалетных кабин не допускает применения абразивных порошков и различных растворителей.
Современные санитарные жидкости хорошо растворяются в любых соотношениях и предотвращают загрязнение накопительного бака. При замерзании сохраняют свои свойства. В их составе нет компонентов, вызывающих старение пластмассы и коррозии металла.
Обзор популярных средств
Разработчики предлагают множество антисептических и дезодорирующих препаратов для чистки фекальных масс.
Микрозим Септи трит
Жидкий концентрат для переработки органических отходов, разжижает и разлагает испражнения на простые химические элементы и углекислый газ, устраняет неприятный запах.
Атмосбио
Биоактиватор подходит для канализационных систем всех типов. Он превращает отходы в твердый минеральный осадок и воду.
Санэкс
Препарат эффективно очищает почву от накопившихся загрязнений и восстанавливает дренажные свойства. Вещество снижает экологическое загрязнение почвы, улучшает дренаж.
Биоактиватор Зеленая сосна
Вещество перерабатывает фекалии при высоких концентрациях и недостатке воды. При попадании в яму антибиотиков, хлора и токсичных веществ действие препарата снижается.
Как почистить увлажнитель воздуха от плесени и накипи, лучшие народные средства и правила
Argus Garden
Средство за короткое время нейтрализует содержимое сборников нечистот. Также предотвращает попадание в почву инфекционных субстанций.
System Septic Mainteiner ДВТ-360
Сухой концентрат нетоксичных бактерий обеспечивает быстрый распад фекалий, уничтожает резкие запахи. Бактерии воздействуют на отходы, перерабатываются в воду и утилизируемые удобрения.
Biodom
Препарат убирает неприятный запах, содержит добавки-катализаторы, ускоряющие процесс утилизации отходов. Помогает восстановить механизм переработки фекалий после очистки с использованием агрессивных химических веществ.
One Flush
Профессиональный препарат для ухода за септическими системами. Супербактерии разлагают и перерабатывают загрязняющие отходы, разлагают углеводороды, серу, целлюлозу.
Девон-Н
Универсальное средство быстро и эффективно устраняет запахи, способствует естественному биологическому разложению органических отходов. Основной компонент порошка – азотное экологически безопасное удобрение.
Доктор Робик
Бактериальное средство очищает сточные воды в локальных системах, утилизирует и компостирует органические отходы. Препарат рекомендуется применять ежемесячно.
Горыныч
Бинарный биопрепарат безопасен для людей, животных и растений. Эффективно и быстро разжижает органику. Переработанные отходы экологически безопасны для компостной кучи.
Примус
Препарат с натуральным составом безопасен для человека и окружающей среды. Продолжительность действия биосредства составляет до 60 дней.
Вейст Трит
Средство разлагает биомассы, устраняет неприятный запах и ускоряет процесс очистки. В состав препарата входит комплекс из шести микроорганизмов, которые проникают внутрь загрязнения и активно борются с ним.
Roetech
Сухое средство разжижает и обезвреживает отходы в септических системах с доступом воздуха. Экологичный, безопасный препарат уменьшает объем твердых фракций. Рекомендуется для аварийной прочистки.
Механические методы прочистки
Если самостоятельно прочистить засор в унитазе при помощи народных или химических средств не удается, то можно прибегнуть к механическому очищению. Процедуру проводят вручную или применяют таких «помощников», как вантуз и сантехнический трос.
Руками
Что делать, если туалет забился инородными предметами: игрушками, тряпками, крупными продуктовыми очистками? Перед тем как устранить засор в унитазе, надо обследовать аварийный участок вручную. Надев на руки перчатки, последовательно выполняют четыре шага.
Вычерпывают из унитаза воду.
Опускают руку в слив и пытаются нащупать посторонний предмет.
Захватывают пальцами мягкие засорения и осторожно вытягивают из унитаза.
Расположенные дальше и более плотные предметы вытаскивают проволокой с крючком на конце.
Иногда после неудачных попыток вытянуть предмет из унитаза, хозяева принимают решение протолкнуть его. Такие действия загоняют пробку значительно глубже и только усугубляют проблему.
Вантузом
Когда причина засорения не была выявлена, а вода еще способна просачиваться, для прочистки унитаза рекомендуется использовать вантуз. Эффективность очищения зависит от правильно выбранного «помощника». В продаже можно встретить несколько разновидностей вантузов.
- Чашеобразный. Это простая модель. Она предназначена для устранения мелкого затора. Чашеобразный вантуз поможет очистить раковину. Но в случае затора в унитазе это средство малоэффективно.
- Конусообразный. Данная модель способна устранить затор в унитазе. Плотная резиновая насадка, обладающая конусообразной формой, обеспечивает правильное вхождение в сливное отверстие.
- Пневматический. Самая совершенная модель, обладающая большой мощностью. Вантуз оборудован насадкой, способной «маневрировать» внутри трубы.
Процедура очищения унитаза вантузом достаточно проста и включает следующие три шага.
- Резиновую насадку ставят на сливное отверстие так, чтобы вантуз полностью закрывал его.
- Для откачивания совершают несколько легких надавливаний (резиновая присоска должна «сцепиться» с отверстием).
- В этот момент резко тянут за ручку, и отрывают насадку от сливного отверстия.
Гидравлический удар при таком приеме обеспечивает очищение от пробки, образованной газетной бумагой, мелкими очистками или иным сором.
Пластиковой бутылкой
Как можно пробить унитаз без вантуза в домашних условиях? Если нужного приспособления нет в хозяйстве, то можно постараться создать гидравлику при помощи обычной пластиковой бутылки. Процесс очищения проводят в четыре этапа.
- У бутылки аккуратно срезают дно.
- На оставшуюся часть плотно завинчивают крышку.
- Пластиковую бутылку срезанной стороной ставят на сливное отверстие.
- Держась за верхнюю часть с крышкой, пытаются создать гидравлический удар как с использованием вантуза.
Сантехническим тросом
Такое мероприятие применяется в самых крайних случаях, когда удалить пробку не удается ни одним из приведенных выше методов. К помощи сантехнического троса прибегают в случае засора канализации строительными отходами (песком, глиной, шпатлевкой), кошачьим наполнителем. Шнек (трос) представляет собой стальную гибкую «змейку», при помощи которой можно достигнуть самых труднодоступных участков канализации. Он оснащен специальной ручкой, обеспечивающей вращение кабеля. Для прочистки унитаза последовательно выполняют семь действий.
Сантехнический трос опускают в сливное отверстие.
Медленно продвигают кабель по изгибам унитаза.
Трос осторожно поворачивают, чтобы он свободно проходил по трубам.
Когда шнек упрется, его начинают вращать, наматывая мусор.
Трос с подцепленным «грузом» осторожно вытягивают из унитаза.
Очистив шнек, его повторно запускают в канализационную трубу.
Повторяют до тех пор, пока полностью не будет устранен затор.
Прочистить унитаз в домашних условиях несложно. Но вряд ли можно назвать эту процедуру приятной. Чтобы не прибегать к необходимости прочищать унитаз, опытные хозяева рекомендуют проводить профилактику. Для этого время от времени необходимо очищать унитаз при помощи соды и уксуса. В этом случае налет и грязь не будут скапливаться, а унитаз всегда будет белоснежным и свежим.
Как убрать старый, ненужный уличный туалет
Перед началом разборки старого помещения подготавливаются инструменты, составляется очередность процесса.
Инструменты для демонтажа
Для того чтобы снести старое сооружение, необходимо запастись инструментами. Для выполнения данной работы не обойтись без кувалды, бензопилы, топора и лома.
Средства защиты
Чтобы не получить ранения во время демонтажа, рекомендуется надеть плотные перчатки, очки, шапку. На ноги необходима обувь с толстой подошвой, чтобы не пораниться старыми торчащими гвоздями.

Порядок сноса своими руками
При разборке сооружения важна последовательность. Некоторые помещения подключены к дачной канализации и септикам, поэтому необходимо выполнять демонтаж так, чтобы не забить сток.
Борьба с запахом
После ликвидации строения может распространяться зловонный запах. Убрать его можно порошковой хлоркой или биоактиваторами. Для этого засыпается или заливается поверхность ямы. Процедура не только убирает запах, но и ускоряет разложение отходов.
Чем засыпать выгребную яму
Старую яму засыпают разными подручными средствами. К таким относятся:
- строительный мусор;
- опилки;
- обрезанные ветви;
- шлак;
- песок.
Воспользоваться можно обычной землей, которая с органикой используется, как плодородный перегной.
Несколько ценных рекомендаций
Если проблемы с выгребной ямой стали возникать чаще, имеет смысл улучшить работу сооружения доступными способами. Некоторые устраивают выгребную яму с переливом, которая функционирует подобно септику. Для этого рядом с уже имеющейся емкостью устраивают еще одну, примерно такую же.
Первая емкость должна быть герметичной, а вторая – проницаемой или без дна. Можно и вторую емкость сделать герметичной, но тогда следует предусмотреть вывод соков на фильтрационное поле или в дренажный колодец. Перелив между этими двумя отделами устанавливают с небольшим уклоном в верхней трети емкостей.
Сначала стоки будут поступать в первый отсек, там они будут отстаиваться, твердые отходы опустятся на дно, а жидкая составляющая канализационного содержимого перельется, когда достигнет нужного уровня.
Во второй отсек попадут, главным образом, жидкие стоки, которые будут быстрее перемещаться на фильтрационное поле для дальнейшей утилизации. В результате яму придется очищать значительно реже, а вероятность заиливания сооружения заметно снизится.

Промерзание канализационных труб происходит чаще всего из-за огрехов во время монтажа. Если это произошло, трубу нужно прогреть, чтобы восстановить работу канализации
В зимний период стоки в выгребной яме могут промерзнуть, что приведет к проблемам в работе канализации. Чтобы исправить ситуацию, замерзшую массу нужно разморозить. Традиционно для этого используют тепловую пушку или ее самодельный аналог. При отсутствии электропитания рядом с промерзшей ямой разводят костры, используют паяльную лампу и т.п.
Для мастеров, имеющих хотя бы небольшой опыт работы с электрикой, доступен еще один способ разморозки выгребной ямы – нагрев непосредственно с помощью электрического тока. Посередине промерзшей выгребной ямы вбивают металлический штырь примерно на глубину промерзания.
Затем необходимо взять электрокабель подходящей длины. Его конец зачищают и присоединяют к штырю, а на противоположный конец подают электропитание 220В.
Для полной разморозки сооружения может понадобиться довольно много времени, порой нужно ждать около суток, все зависит от размеров ямы. При выполнении такого рода работ в обязательном порядке следует выполнять требования электротехнической безопасности, например, использовать защитные резиновые перчатки, обувь и т.п.
Если промерзает не яма, а ведущая к ней канализационная труба, это указывает на огрехи при прокладке коммуникаций, например, траншея оказалась недостаточно глубокой или отсутствует утепление. Исправить эти проблемы можно летом, а во время холодов следует позаботиться о размораживании труб.
Для этого также можно использовать электрический ток. На конце кабеля нужно зачистить отрезок, равный длине окружности трубы. Чтобы вычислить это значение, нужно просто диаметр трубы умножить на 3,14, т.е. на число “пи”.
Затем защищенный провод наматывают вокруг промерзшей трубы. На кабель подают электропитание, через пару часов такого нагрева содержимое трубы растает, и работа канализационной системы возобновится.
Биологическое оружие на страже чистоты
Если ваша душевная организация несовместима с ручным способом утилизации сточных вод, на помощь придут живые бактерии. Биопрепараты, которые за рубежом применяются вот уже полвека, у нас стали распространяться чуть больше 15 лет назад. Ценность бактерий очевидна: если правильно подобрать средство, можно очистить дачный туалет, свести к минимуму применение откачки, а также обеспечить огород безопасным качественным удобрением.
Как биопрепараты действуют
Биопрепараты содержат активные (живые) бактерии, способные жить в жидкой среде. Работа бактерий сводится к ускорению естественных процессов разложения, происходящих в выгребной яме. Они питаются органикой, то есть, разлагают ее в процессе брожения, оставляя чистую воду и илистый осадок.

Бактерии помогают сэкономить на откачке Источник yandex.net
Бактерии существуют и выполняют работу по утилизации в диапазоне температур от +4 до +40°C. Их гастрономические интересы распространяются не только на органику (включая бумагу, очистки овощей), но и на микроорганизмы, ответственные за неприятный запах. Некоторые виды способны расщеплять мыло и другие моющие средства, что позволяет эффективно очистить уличный туалет в частном доме без откачки.
Производители предлагают препараты в разной форме: таблетки, порошок, гранулы (их надо растворять в воде перед использованием), или в виде жидкого концентрата. Они содержат бактерии двух видов:
- Анаэробные. Обходятся без кислорода, чаще используются в септиках закрытого вида.
- Аэробные. Для нормальной жизнедеятельности необходим кислород, подходят для приведения в порядок выгребной ямы.
Биохимическая очистка (разложение стоков на ил и воду) происходит в два приема. Сначала анаэробные бактерии окисляют органику, затем аэробы проводят доочистку. После биологической переработки остается очищенная вода, которая просачивается в грунт, или выкачивается насосом и используется в хозяйстве (для полива, обустройства декоративного водоема).

Препараты с разным спектром действия Источник ytimg.com
На дне остается ил, который после извлечения и выдержки в компостной куче превратится в удобрение. Регулярное применение био-очистителя позволяет привести в порядок дренажную систему выгребной ямы; исключается проблема заиливания и вызова ассенизаторской машины.
Плюсы и минусы использования бактерий
Желая почистить уличный туалет в частном доме, и делая выбор в пользу биопрепаратов, вы получаете следующие преимущества:
- Одна порция рассчитана на долгий срок действия, примерно на месяц работы. Затем достаточно поддерживать результат.
- Бактерии безвредны для человека и окружающей среды, а и результат их деятельности (илистый осадок) – побочный продукт, которым удобряют почву.
- Дополнительные эффекты. После использования биосредства уменьшается запах, сокращается популяция мух.
- Облегчается откачка механическими средствами, так как придонный слой отходов не уплотняется.
- При использовании средств на основе бактерий необходимо помнить о следующих недостатках:
- Большая часть биопрепаратов не эффективна в зимнее время, так как бактерии живут при плюсовых температурах.
Производители подбирают микроорганизмы с определенными свойствами Источник wp.com
Бактерии чувствительны к химическим соединениям (хлор, марганец); в их присутствии начинают плохо работать, могут погибнуть. Поэтому в яму с бактериями не рекомендуется сливать продукты бытовой химии, антибактериальные лекарственные препараты или одновременно использовать химические препараты для очистки.
Как понять, что нужно чистить туалет на даче

Туалет стоит в укромном месте на даче, отдаленном по максимуму от жилой зоны. О его существовании вспоминают во время потребности. Следить за наполнением выгребной ямы хозяин забывает. Поднятие нечистот выше критического уровня приносит большие проблемы. По участку распространяется едкий неприятный запах. В результате, туалетом на даче становится невозможно пользоваться.
Стандартный объем выгребной ямы – от 1,5 до 2 м 3 . На даче она заполнится примерно через 7-10 лет. Вручную вычистить большое количество нечистот тяжело. Процесс усложняется затвердеванием содержимого ямы, так как жидкость зимой замерзает, а летом испаряется и впитывается в грунт.
При возможности механической очистки ассенизаторской машиной, допускается реже выполнять откачку. Услуга дорого стоит и заказывает ее ежегодно невыгодно. Сроки выкачки определяют визуальным наблюдением за наполнением ямы. Однако до крайних пределов допускать нельзя из-за возникновения последствий:
- Переполненная нечистотами яма служит источником жизнедеятельности и размножения вредных микроорганизмов. Происходит заражение почвы. Микробы способны проникнуть в организм человека.
- Летом в жару нечистоты начинают бродить. Образуется большое выделение ядовитых газов. Дача превращается из зоны отдыха в ненавистное место, так как избавиться от неприятных запахов практически невозможно.
Наступление срока необходимости чистки туалета владелец дачи определяет самостоятельно. Все зависит от размеров выгребной ямы, частоты пользования, количества проживающих людей.
Четыре основных способа очистки

Существует много народных способов, как почистить уличный туалет, но на них мы останавливаться не будем, а рассмотрим проверенные временем варианты:
- Самым надежным способом чистки уличного туалета является вызов ассенизаторской машины . Услуга эффективна в случае переполнения выгребной ямы, когда биологические и химические препараты не способны справиться с большой массой отходов. Машина с помощью вакуумного насоса выкачивает все нечистоты в цистерну. Агрегаты, укомплектованные режущим механизмом, способны даже перемалывать твердые фракции и предметы, случайно попавшие в выгребную яму. Процесс откачки отходов сопровождается неприятным запахом, но с большими объемами ассенизаторская машина быстро справляется.
- Очищать уличный туалет химическими препаратами желательно только в крайних случаях . Они эффективны, и действуют даже зимой, когда бактерии биопрепаратов не работают. Но большинство химических средств создают угрозу окружающей среде. К тому же после их использования твердые нечистоты разжижаются и их все равно куда-то надо девать. На огород выливать нельзя, для компоста такие отходы вредные, поэтому вновь придется прибегать к найму ассенизаторской машины. Из химических препаратов самыми безопасными считаются нитратные окислители.
- Биопрепараты содержат комплекс полезных бактерий, помогающих переработать отходы в уличном туалете. После их применения нечистоты расщепляются на безопасный ил и жидкость. Переработанные отходы можно использовать вместо удобрения или просто сливать в отведенное на дачном участке место. Недостатком применения бактерий является их боязнь низкой температуры и агрессивной среды. Если в яму попали кислоты, щелочь, хлор или температура воздуха опустилась до отрицательной отметки, бактерии погибают.
- Самым распространенным способом считается механическая чистка туалета своими руками . Процедура очень неприятная, так как подразумевает черпание отходов из уличного туалета ведрами и другими приспособлениями. Эту работу лучше проводить ежегодно, так как с большими объемами вручную справиться трудно. Если нечистоты слишком жидкие их смешивают с древесными опилками или торфом.
Каждый хозяин индивидуально подбирает способ, как очистить на своем участке уличный туалет. А мы сейчас постараемся вкратце охватить несколько способов удаления отходов.
Что представляют из себя препараты для очистки дачного туалета? Как ими пользоваться?
Мы говорим о биологических веществах, именуются которые бактерии. Данные добавки весьма активно взаимодействуют со всеми органическими составляющими выгребной ямы либо же туалета, вследствие чего и происходит очистка туалета на даче.
Бактерии для туалета
Перед тем, как очистить туалет на даче подобными веществами тщательно изучите условия их использования, а также проконсультируйтесь с профессионалами, которых вы можете встретить в магазинах. Опишите им особенности вашего туалета, грунт, климатические условия и тому подобное.
Обратите внимание на то, что бактерии крайне чувствительны к отдельным химическим соединениям, среди них:
- Все соединения, которые содержат хлор;
- Щелочи в любом виде;
- Альдегидные, а также кислотные вещества;
- Все соединения фенолов.
Во всем мире препараты данного вида пользуются невероятным спросом на протяжении уже многих десятков лет, но, неизвестно по каким причинам, никак не займут лидирующую позицию на рынках стран СНГ.
Как рассчитать требуемую высоту подъема
Выбирая фекальный насос для канализации необходимо обращать внимание на две характеристики: его мощность (производительность) и высоту подъема. С производительностью все более-менее понятно — она зависит от объемов, которые необходимо перекачивать. Высоту подъема придется считать, ведь кроме вертикальной составляющей, с которой все понятно (это глубина колодца/септика, с которой надо поднимать стоки), есть еще горизонтальная составляющая — эти стоки надо куда-то передать, обычно в какую-то емкость
То расстояние, на которое надо передать стоки в горизонтальной плоскости делят на 10. Результат прибавляют к высоте подъема из колодца
Высоту подъема придется считать, ведь кроме вертикальной составляющей, с которой все понятно (это глубина колодца/септика, с которой надо поднимать стоки), есть еще горизонтальная составляющая — эти стоки надо куда-то передать, обычно в какую-то емкость. То расстояние, на которое надо передать стоки в горизонтальной плоскости делят на 10. Результат прибавляют к высоте подъема из колодца.
Пример технических характеристик фекального насоса для откачки канализации
Например, глубина колодца 4 метра, передать надо стоки на 35 метров. Итого получаем: 4 м + 35 м / 10 = 7,5 м. В технических характеристиках насоса должна быть высота подъема не менее этой цифры, а лучше на 20-25% больше, чтобы оборудование не работало на пределе, что ведет к преждевременному износу. Теперь вы знаете, как рассчитать фекальный насос для канализации.
Сухие туалеты на улице
Сухие туалеты – это особый вид отхожего места, в которых не используют воду. Их выбирают многие дачники, так как ухаживать за ними очень просто. Используют такие приспособления как в доме, так и на улице.
Основные разновидности:
- Туалеты с компостированием. В них отходы полностью превращаются в компост, который практичные садоводы используют на участке в качестве удобрения.
- Сухие туалеты с раздельным забором мочи. Они отделяют фекалии от урины по разным контейнерам.
- Сухие туалеты с химическим наполнителем. Они имеют небольшие размеры и подходят для непродолжительного использования.
- Туалеты с разными типами ликвидации отходов: со сжиганием, упаковкой и заморозкой. Эти устройства практичны в применении, но отличаются высокой стоимостью, которая может превышать 50 000 рублей.
Главное преимущество всех сухих туалетов – это отсутствие запаха.



































